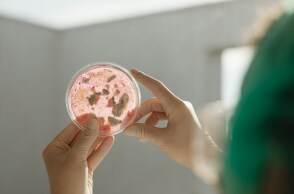
Βακτήρια σε εργαστήριο

- CITY GUIDE
- PODCAST
-
 17°
17°
Vibrio: Το βακτήριο που τρέφεται με ανθρώπινη σάρκα προκάλεσε 8 θανάτους
Προειδοποίηση των υγειονομικών αρχών προς τους κατοίκους των παράκτιων αμερικανικών πολιτειών


Πού εντοπίζεται το επικίνδυνο βακτήριο – Τα λάθη των λουομένων
Η επιστημονική του ονομασία είναι Vibrio vulnificus και πρόκειται για το σαρκοφάγο βακτήριο ποιυ μέχρι στιγμής έχει προκαλέσει τον θάνατο 8 ατόμων και έχει αρρωστήσει άλλους 32 ανθρώπους κατά μήκος των παράκτιων πολιτειών της Αμερικής.
Οι υγειονομικές αρχές εκπέμπουν προειδοποίηση στους κατοίκους των συγκεκριμένων πολιτειών της ακτής του Κόλπου, μετά τον θάνατο οκτώ ατόμων από το σαρκοφάγο βακτήριο.
Επιπλέον, τέσσερις περιπτώσεις κατέληξαν σε θάνατο. Περίπου το 75% αυτών των περιπτώσεων οφειλόταν σε μόλυνση τραυμάτων από θαλασσινό νερό.
Και το Υπουργείο Υγείας της Φλόριντα επιβεβαίωσε 13 περιπτώσεις και τέσσερις θανάτους από Vibrio φέτος. Τόσο ο Μισισιπής όσο και η Αλαμπάμα έχουν επίσης αναφέρει μεμονωμένες περιπτώσεις, καμία από τις οποίες δεν ήταν θανατηφόρα.
Οι υγειονομικές αρχές ενθαρρύνουν τους κατοίκους να ενημερωθούν προκειμένου να παραμείνουν ασφαλείς κατά τη διάρκεια των καλοκαιρινών μηνών.
Πού εντοπίζεται το επικίνδυνο βακτήριο
Το Vibrio ζει φυσιολογικά στα παράκτια νερά, σύμφωνα με το Κέντρο Ελέγχου και Πρόληψης Νοσημάτων. Οι περισσότεροι άνθρωποι αρρωσταίνουν από το vibrio μετά την κατανάλωση ωμών ή μη καλά μαγειρεμένων οστρακοειδών — ιδιαίτερα στρειδιών — επειδή τα βακτήρια «συγκεντρώνονται» μέσα στα οστρακοειδή, εξηγεί το CDC. Ωστόσο, ζουν φυσιολογικά σε υφάλμυρο νερό και προκαλούν λοίμωξη εάν το άτομο που απολαμβάνει το μπάνιο του φέρει ανοιχτή πληγή — πρόσφατο τατουάζ ή piercing.
Τα συμπτώματα μιας λοίμωξης από Vibrio ποικίλλουν, ανάλογα με τον τρόπο μόλυνσης από το βακτήριο.
Για τις λοιμώξεις του αίματος, το CDC αναφέρει ότι κάποιος μπορεί να παρουσιάσει «πυρετό, ρίγη, επικίνδυνα χαμηλή αρτηριακή πίεση και φουσκάλες στο δέρμα». Ωστόσο, για μια λοίμωξη τραύματος, ο πυρετός θα συνοδεύεται από πρήξιμο και έκκριση γύρω από το τραύμα. Και για όσους καταπιούν το βακτήριο, μπορεί να μοιάζει με τροφική δηλητηρίαση, με συμπτώματα διάρροιας, «που συχνά συνοδεύεται από κράμπες στο στομάχι, ναυτία, έμετο και πυρετό».
Το CDC αναφέρει ότι η λοίμωξη από Vibrio είναι θεραπεύσιμη με αντιβιοτικά, αλλά σε πιο σοβαρές περιπτώσεις, «οι γιατροί μπορεί να χρειαστεί να ακρωτηριάσουν τα πόδια ή τα χέρια ενός ασθενούς για να αφαιρέσουν νεκρό ή μολυσμένο ιστό».
Με στοιχεία από USA Today, NBCnews
ΤΑ ΠΙΟ ΔΗΜΟΦΙΛΗ

ΔΙΑΒΑΖΟΝΤΑΙ ΠΑΝΤΑ
ΔΕΙΤΕ ΕΠΙΣΗΣ
Tι αναφέρουν για την αντισημιτική επίθεση
Φέρεται να εθεάθη μαζί με τον επιχειρηματία Μπλέικ Γουίν
Kατέγραφαν βίντεο με τα κινητά τους τηλέφωνα και εισέπνεαν νιτρώδες οξείδιο, γνωστό και ως «αέριο γέλιου»
Νεκρός, εκατοντάδες τραυματίες και 780 συλλήψεις μετά τους πανηγυρισμούς για το Champions League – Στο επίκεντρο η διαχείριση πλήθους και η βία στα γαλλικά προάστια.
Αντίποινα με drones και πυραύλους
Eκτιμά ότι η χώρα του βρίσκεται πλέον σε πιο ευνοϊκή στρατηγική θέση
Οι αρχές ανακοίνωσαν ότι 57 αστυνομικοί τραυματίστηκαν
Η κρίση αποδίδεται σε συνδυασμό παραγόντων
H νέα πραγματικότητα προκαλέσει σοβαρές αναταράξεις στην τοπική αλιευτική βιομηχανία
Τα επεισόδια ξέσπασαν στην περιοχή Πορτονόβα, βόρεια της Αυλώνας
Tο Παρίσι κάνει λόγο για «μεγάλο λάθος» του Μπενιαμίν Νετανιάχου
Οι αρχές σφράγισαν το κατάστημα για διοργάνωση μουσικών εκδηλώσεων που προωθούσε «παρεκκλίνουσες συμπεριφορές»
Η χώρα ψηφίζει στον πρώτο γύρο εν μέσω του χειρότερου κύματος βίας από το 2016
Ο Αμερικανός πρόεδρος σκληραίνει τη στάση του για τα πυρηνικά και τα Στενά του Ορμούζ
Τέσσερις τραυματίες
Aφού παραδέχθηκε τρεις κατηγορίες που αφορούσαν άσεμνο υλικό με ανηλίκους
Ανθρωποκυνηγητό για τον δράστη
Το ζήτημα αποκτά ιδιαίτερη σημασία δεδομένου ότι ο πρόεδρος πλησιάζει τα 80 χρόνια
Aρκετοί επιστήμονες εκφράζουν επιφυλάξεις για τα αποτελέσματα
Οι δύο καλλιτέχνες επρόκειτο να εμφανιστούν στο φεστιβάλ «Pulse of Gaia»
Έχετε δει 20 από 200 άρθρα.